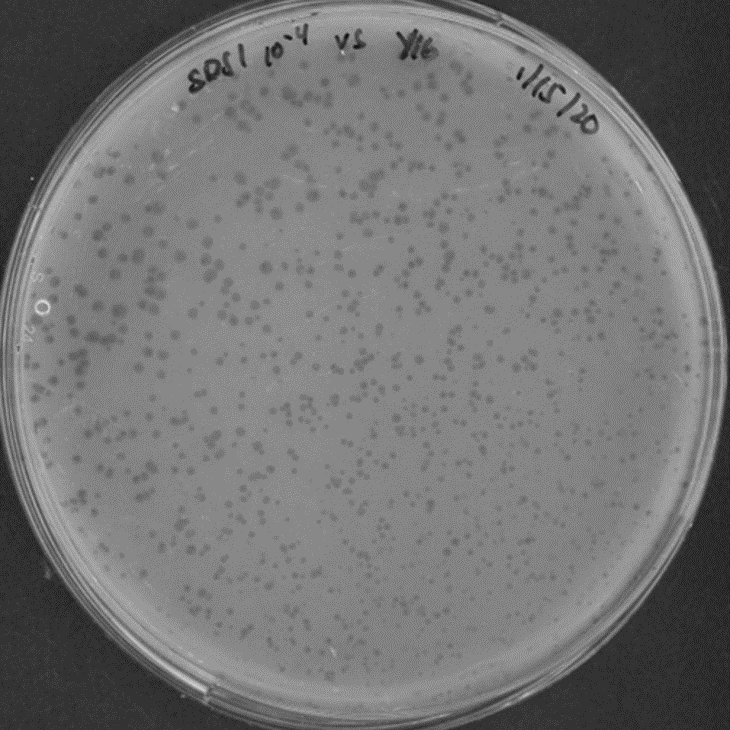
Plaque Assay

Apr 16, 2020
Plaque Assay
- Alice Lee1
- 1UCI
- Whiteson Lab - Phage Team

Protocol Citation: Alice Lee 2020. Plaque Assay. protocols.io https://dx.doi.org/10.17504/protocols.io.be6sjhee
License: This is an open access protocol distributed under the terms of the Creative Commons Attribution License, which permits unrestricted use, distribution, and reproduction in any medium, provided the original author and source are credited
Protocol status: Working
We use this protocol and it's working
Created: April 15, 2020
Last Modified: April 16, 2020
Protocol Integer ID: 35762
Keywords: plaque, assays, bacteriophages, phages, plaque assay bacteriophage, plaque assay, performing plaque assay, phage, bacteria, assay, viral concentration, virus,
Abstract
Bacteriophages (phage) are viruses that infect bacteria and can be found anywhere that bacteria is found. Performing plaque assays is a technique to purify a population of viruses and can also be used to determine the viral concentration of a given sample. This protocol will outline the steps to carry out plaque assays.
Materials
MATERIALS
Brain Heart Infusion BrothMerck MilliporeSigma (Sigma-Aldrich)Catalog #53286-500G
UltraPure LMP AgaroseInvitrogen - Thermo FisherCatalog #16520-050
AgarCatalog #BP9744-2
SM Buffer
Snap Cap Tubes, Disposable Inoculating Loops, Shaker, 37C incubator, Petri Plates, Glass Tubes, Serological Pipette, 5mL Disposable Serological Pipette Tips, 1.5uL tubes, Microwave
Troubleshooting
Safety warnings
- PPE should be worn at all times (i.e. gloves, lab coat, safety glasses)
- Work with phages should be performed in BSL2
Before start
- Make BHI plates
- Make BHI broth media
- Make BHI + 0.35% LMP agarose
- Make SM buffer
Inoculating a liquid bacterial culture overnight
13h
The day before performing the plaque assay experiment, grow the bacteria associated with the phage of interest.
13h
Take out an already streaked bacteria plate from the 4 °C room.
This is an example of how a streak plate of your bacteria should look like.
1m
Take a snap cap tube and place it on a rack. Open the cap and aseptically transfer 2 mL of BHI media into the tube.
2m
Take a disposable inoculating loop and scrape a colony from your bacteria streak plate and transfer into the snap cap tube with 2 mL of BHI media. Recap the snap cap tube and throw the used inoculating loop in the red biohazard bin.
3m
Transfer the snap cap tube to the 37 °C incubator room and place it on the shaker. Then turn the shaker on to 200 rpm . When leaving the room, remember to turn off the light switch on the outside of the room.
5m
Grow the bacteria on 37 °C shaker overnight.
12h
Inoculating liquid bacterial culture day of experiment
3h
The day of the experiment, take the overnight grown bacteria and transfer to fresh media to grow so that we will be working with log-phase bacteria.
Take a new snap cap tube and aseptically add2 mL of fresh BHI media into the tube.
Take the overnight grown bacteria from the 37 °C incubator. Aseptically transfer 100 µL of the overnight culture into the new tube with 2 mL of BHI media.
Transfer this snap cap tube to the 37 °C incubator room and place it on the shaker. Then turn on the shaker to 200 rpm .
Incubate the sample on the shaker for ~3 hours or until the sample has become cloudy indicating bacterial growth.
Preparing BHI plates
20m
Take out the required number of BHI plates from the 4 °C incubator room. Wipe down the hood with 70% ethanol. Place the plates inside the hood with the lid halfway open. This will dry out the liquid droplets from the plate.
Phage Serial Dilution
30m
In order to determine the concentration of the phage stock, you will need to perform a serial dilution of the stock.
Example of a 10-fold dilution series.
Take the phage stock tube from the -80 °C freezer and let it thaw at room temperature. The location of the phage stocks can be determined by looking at the MissionControl document on Google Drive.
To perform a 1:10 dilution of the stock sample, add 90 µL of SM buffer into a 1.5mL tube then add 10 µL of the stock phage into the tube. Mix well.
To perform a 1:100 dilution of the stock sample, add 90 µL of SM buffer into a 1.5mL tube then add 10 µL of the 1:10 phage dilution from Step 4.2 into the tube. Mix well.
Continue performing the serial dilutions for how many samples you will be observing.
Create a tube for the negative control by adding 90 µL of SM buffer and 10 µL of Ultra Pure Water (UPW) into a 1.5mL tube.
Plaque Assay
2h
Combine the log phase bacteria and serially diluted phages then plate them.
Take a bottle of BHI + 0.35% LMP agarose and microwave until boil. The microwave is located in BSL1 so make sure to remove all BSL2 PPE before entering BSL1.
Start off with 00:00:30 then gradually add more time to prevent boil over of the media onto the microwave. Use paper towels or an autoclave glove to handle the glassware and transfer it back to BSL2.
10m
Ensure that the BHI + 0.35% LMP agarose cools down before using it or it may heat shock the bacteria and kill it.
15m
Take a glass culture tube and label it appropriately with the sample.
Add 100 µL of log-phase bacteria from Step 2 into the glass tube. Then add 10 µL of the phage dilution into the same glass tube. Let sit for 15-20 minutes.
20m
Use a serological pipette and measure 3.5 mL of cooled down BHI + 0.35% LMP agarose. Aseptically transfer to the glass tube and mix by pipetting up and down but not quickly to prevent any bubble formation.
Transfer the contents of the glass tube onto a dried BHI plate and swirl the plate around to properly disperse the contents.
There is a green taped X mark on the sink counter which is leveled. Place the plate on top of the X mark and let it solidify.
Continue for the rest of the samples. Don't forget to always perform a negative control plate.
After the plates have solidified, store in the 37 °C incubator upside down. Incubate overnight.
Determine the phage concentration
30m
The next day, observe the plates to determine the concentration of the viral sample from the stock.
Look at the plates and find one where there are enough phage forming units (PFU) that can be counted. Count the number of plaques on the plate.
Use this formula:
PFU/uL = Number of Plaques Counted/ (Dilution x Volume of Diluted Virus Added)
Example: There are 28 plaques on a 10^-2 phage dilution plate. You had plated 10uL of this along with 100uL of bacteria.
28/10^-2 x 10uL = 280 = 2.8 x 10^2 PFU/uL
